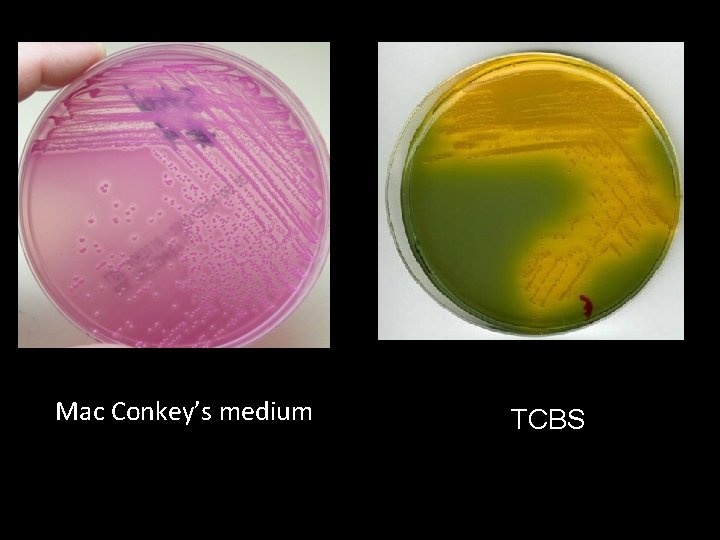
Mac Conkey’s medium TCBS
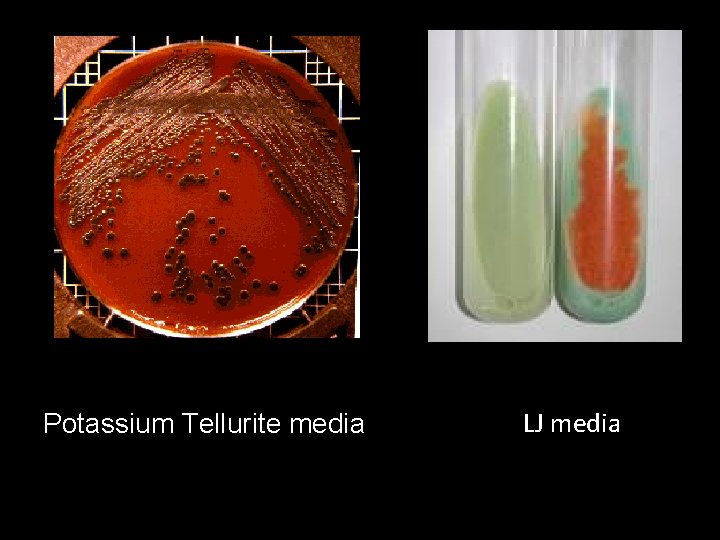
Potassium Tellurite media LJ media
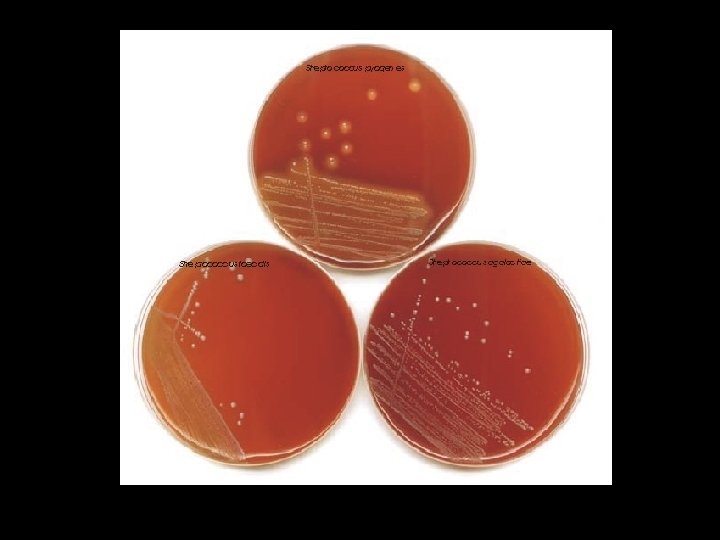
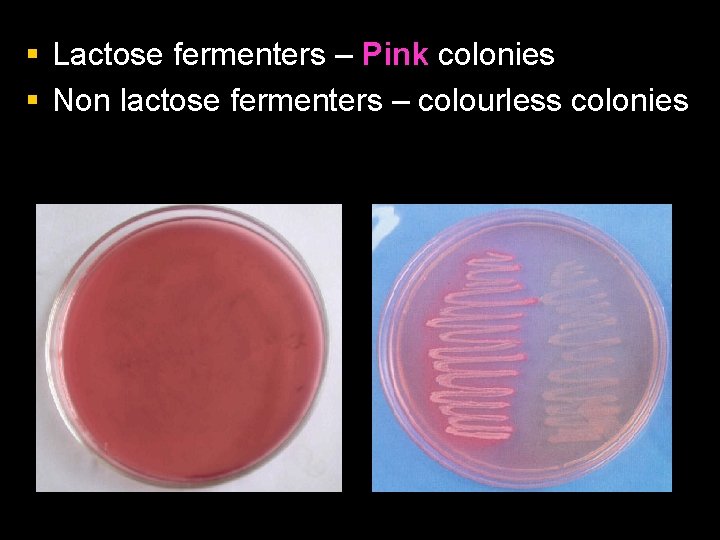
§ Lactose fermenters – Pink colonies § Non lactose fermenters – colourless colonies
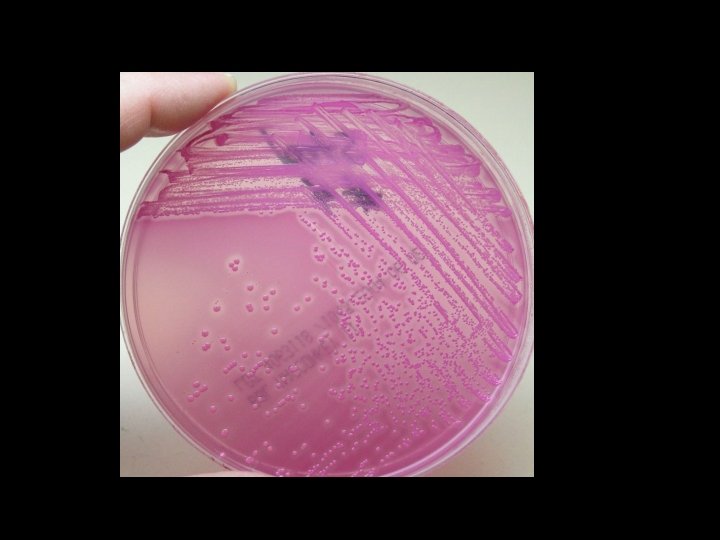

Culture Media AMAR SUNIL LOBO Lecturer Dept of

Culture Media AMAR SUNIL LOBO Lecturer, Dept. of Microbiology Yenepoya Medical College

CULTURE MEDIA & CULTURE METHODS

§ Bacteria have to be grown (cultured) for them to be identified. § By appropriate procedures they have to be grown separately (isolated) on culture media and obtained as pure for study. History § The original media used by Louis Pasteur – urine or meat broth § Liquid medium – diffuse growth § Solid medium – discrete colonies.

Colony – macroscopically visible collection of millions of bacteria originating from a single bacterial cell. § Cooked cut potato by Robert Koch – earliest solid medium § Gelatin – not satisfactory - liquefy at 24 o. C

Agar § Frau Hesse § Used for preparing solid medium § Obtained from seaweeds. § No nutritive value § Not affected by the growth of the bacteria. § Melts at 98 o. C & sets at 42 o. C § 2% agar is employed in solid medium

Types of culture media I. II. Based on their consistency a) solid medium b) liquid medium c) semi solid medium Based on the constituents/ ingredients a) simple medium b) complex medium c) synthetic or defined medium d) Special media

Special media – – – – Enriched media Enrichment media Selective media Indicator media Differential media Sugar media Transport media Media for biochemical reactions III. Based on Oxygen requirement - Aerobic media - Anaerobic media

Solid media – contains 2% agar § Colony morphology, pigmentation, hemolysis can be appreciated. § Eg: Nutrient agar, Blood agar Liquid media – no agar. § For inoculum preparation, Blood culture, for the isolation of pathogens from a mixture. § Eg: Nutrient broth Semi solid medium – 0. 5% agar. § Eg: Motility medium


Simple media / basal media - Eg: NB, NA - NB consists of peptone, meat extract, Na. Cl, - NB + 2% agar = Nutrient agar

Complex media § Media other than basal media. § They have added ingredients. § Provide special nutrients Synthetic or defined media § Media prepared from pure chemical substances and its exact composition is known § Eg: peptone water – 1% peptone + 0. 5% Na. Cl in water

Enriched media § Substances like blood, serum, egg are added to the basal medium. § Used to grow bacteria that are exacting in their nutritional needs. § Eg: Blood agar, Chocolate agar

Blood agar Chocolate agar

Enrichment media § Liquid media used to isolate pathogens from a mixed culture. § Media is incorporated with inhibitory substances to suppress the unwanted organism. § Eg: – Selenite F Broth – for the isolation of Salmonella, Shigella – Alkaline Peptone Water – for Vibrio cholerae

Selective media § The inhibitory substance is added to a solid media. Eg: § Mac Conkey’s medium for gram negative bacteria § TCBS – for V. cholerae § LJ medium – M. tuberculosis § Wilson and Blair medium – S. typhi § Potassium tellurite medium – Diphtheria bacilli
Mac Conkey’s medium TCBS
Potassium Tellurite media LJ media

Indicator media § These media contain an indicator which changes its colour when a bacterium grows in them. § Eg: – Blood agar – Mac Conkey’s medium – Christensen’s urease medium

Urease medium

Differential media § A media which has substances incorporated in it enabling it to distinguish between bacteria. § Eg: Mac Conkey’s medium – Peptone – Lactose – Agar – Neutral red – Taurocholate § Distinguish between lactose fermenters & non lactose fermenters.
§ Lactose fermenters – Pink colonies § Non lactose fermenters – colourless colonies

Sugar media § Media containing any fermentable substance. § Eg: glucose, arabinose, lactose, starch etc. § Media consists of 1% of the sugar in peptone water. § Contain a small tube (Durham’s tube) for the detection of gas by the bacteria.


Transport media § Media used for transporting the samples. § Delicate organisms may not survive the time taken for transporting the specimen without a transport media. § Eg: – Stuart’s medium – non nutrient soft agar gel containing a reducing agent – Buffered glycerol saline – enteric bacilli

Anaerobic media § These media are used to grow anaerobic organisms. § Eg: Robertson’s cooked meat medium, Thioglycolate medium.

BIOCHEMICAL TEST & REACTIONS § They provide additional information for the identification of the bacterium. § The tests include: – Oxidase test – Triple sugar iron agar (TSI) – Indole test – Citrate utilization – Urease test

OXIDASE TEST § Detects the presence of an enzyme “oxidase” produced by certain bacteria which will reduce the dye – tetramethyl-p-phenylene diamine dihydrochloride. § Positive test is indicated by the development of a purple colour. § Oxidase positive – Pseudomonas, Vibrio, Neisseriae § Oxidase negative – Salmonella, Shigella


TRIPLE SUGAR IRON AGAR (TSI) § It is a composite media used to study different properties of a bacterium – sugar fermentation, gas production and H 2 S production. § In addition to peptone, yeast extract & agar, it contains 3 sugars – Glucose, Lactose, Sucrose. § The Iron salt – Ferric citrate indicates H 2 S production. § Phenol red is the indicator. § It is an orange red medium with a slant and a butt. § p. H of the medium – 7. 4

TSI REACTIONS: § § § § Yellow – Acid Pink - Alkaline Yellow slant / Yellow butt (A/A) – Lactose fermenters. Pink slant / Yellow butt (K/A) – Non lactose fermenters. Pink slant / no colour change (K/K) – Non fermenters Black colour – H 2 S production. Gas bubbles or crack in the medium – gas production. LF – E. coli, Klebsiella NLF – Salmonella, Shigella H 2 S - Proteus


INDOLE TEST § Used to detect indole production by the organism. § They produce indole from tryptophan present in peptone water. § After overnight incubation, a few drops of indole reagent (Kovac’s reagent) is added. § Positive test is indicated by a pink ring. – Positive indole test – pink ring – Negative indole test - yellow ring § Indole positive – E. coli § Indole negative – Klebsiella, Salmonella.


CITRATE UTILIZATION § Done in Simmon’s Citrate medium. § To detect the ability of certain bacteria to utilize citrate as the sole source of carbon. § Contains Sodium citrate and bromothymol blue as the indicator. § If citrate is utilized, alkali is produced which turns the medium to blue. – Citrate positive – blue colour – Citrate negative – green colour § Positive – Klebsiella § Negative – E. coli


UREASE TEST § Done in Christensen’s urease medium. § This test is used to detect organisms that produce urease. § Urease produced by the organisms split urea into ammonia and CO 2. – Urease positive – pink colour – Urease negative – yellow colour § Positive – Proteus, Klebsiella § Negative – E. coli, Salmonella


CULTURE METHODS § Culture methods employed depend on the purpose for which they are intended. § The indications for culture are: – To isolate bacteria in pure cultures. – To demonstrate their properties. – To obtain sufficient growth for the preparation of antigens and for other tests. – For bacteriophage & bacteriocin susceptibility. – To determine sensitivity to antibiotics. – To estimate viable counts. – Maintain stock cultures.

Culture methods include: § Streak culture § Lawn culture § Stroke culture § Stab culture § Pour plate method § Liquid culture § Anaerobic culture methods

STREAK CULTURE § Used for the isolation of bacteria in pure culture from clinical specimens. § Platinum wire or Nichrome wire is used. § One loopful of the specimen is transferred onto the surface of a well dried plate. § Spread over a small area at the periphery. § The inoculum is then distributed thinly over the plate by streaking it with a loop in a series of parallel lines in different segments of the plate. § On incubation, separated colonies are obtained over the last series of streaks.

LAWN CULTURE § Provides a uniform surface growth of the bacterium. § Uses – For bacteriophage typing. – Antibiotic sensitivity testing. – In the preparation of bacterial antigens and vaccines. § Lawn cultures are prepared by flooding the surface of the plate with a liquid suspension of the bacterium.

Antibiotic sensitivity testing

STROKE CULTURE § Stroke culture is made in tubes containing agar slope / slant. § Uses – Provide a pure growth of bacterium for slide agglutination and other diagnostic tests.

STAB CULTURE § Prepared by puncturing a suitable medium – gelatin or glucose agar with a long, straight, charged wire. § Uses – Demonstration of gelatin liquefaction. – Oxygen requirements of the bacterium under study. – Maintenance of stoke cultures.

Gelatin liquefaction Oxidation – Fermentation medium

POUR PLATE CULTURE § Agar medium is melted (15 ml) and cooled to 45 o. C. § 1 ml of the inoculum is added to the molten agar. § Mix well and pour to a sterile petri dish. § Allow it to set. § Incubate at 37 o. C, colonies will be distributed throughout the depth of the medium. § Uses – Gives an estimate of the viable bacterial count in a suspension. – For the quantitative urine cultures.

LIQUID CULTURES § Liquid cultures are inoculated by touching with a charged loop or by adding the inoculum with pipettes or syringes. § Uses – Blood culture – Sterility tests – Continuous culture methods § Disadvantage – It does not provide a pure culture from mixed inocula.

Blood culture bottles

ANAEROBIC CULTURE METHODS § Anaerobic bacteria differ in their requirement and sensitivity to oxygen. § Cl. tetani is a strict anaerobe – grows at an oxygen tension < 2 mm Hg. Methods: – Production of vacuum – Displacement of oxygen with other gases – Chemical method – Biological method – Reduction of medium

Production of vacuum: § Incubate the cultures in a vacuum desiccator. Displacement of oxygen with other gases § Displacement of oxygen with hydrogen, nitrogen, helium or CO 2. § Eg: Candle jar


Chemical method § Alkaline pyrogallol absorbs oxygen. Mc. Intosh – Fildes’ anaerobic jar § Consists of a metal jar or glass jar with a metal lid which can be clamped air tight. § The lid has 2 tubes – gas inlet and gas outlet § The lid has two terminals – connected to electrical supply. § Under the lid – small grooved porcelain spool, wrapped with a layer of palladinised asbestos.


Working: § Inoculated plates are placed inside the jar and the lid clamped air tight. § The outlet tube is connected to a vacuum pump and the air inside is evacuated. § The outlet tap is then closed and the inlet tube is connected to a hydrogen supply. § After the jar is filled with hydrogen, the electric terminals are connected to a current supply, so that the palladinised asbestos is heated. § Act as a catalyst for the combination of hydrogen with residual oxygen.

Gaspak § Commercially available disposable envelope. § Contains chemicals which generate H 2 and CO 2 on addition of water. § Cold catalyst – in the envelope § Indicator is used – reduced methylene blue. – Colourless – anaerobically – Blue colour – on exposure to oxygen


Biological method § Absorption of oxygen by incubation with aerobic bacteria, germinating seeds or chopped vegetables. Reduction of oxygen § By using reducing agents – 1% glucose, 0. 1% Thioglycolate

THANK YOU
- Slides: 61